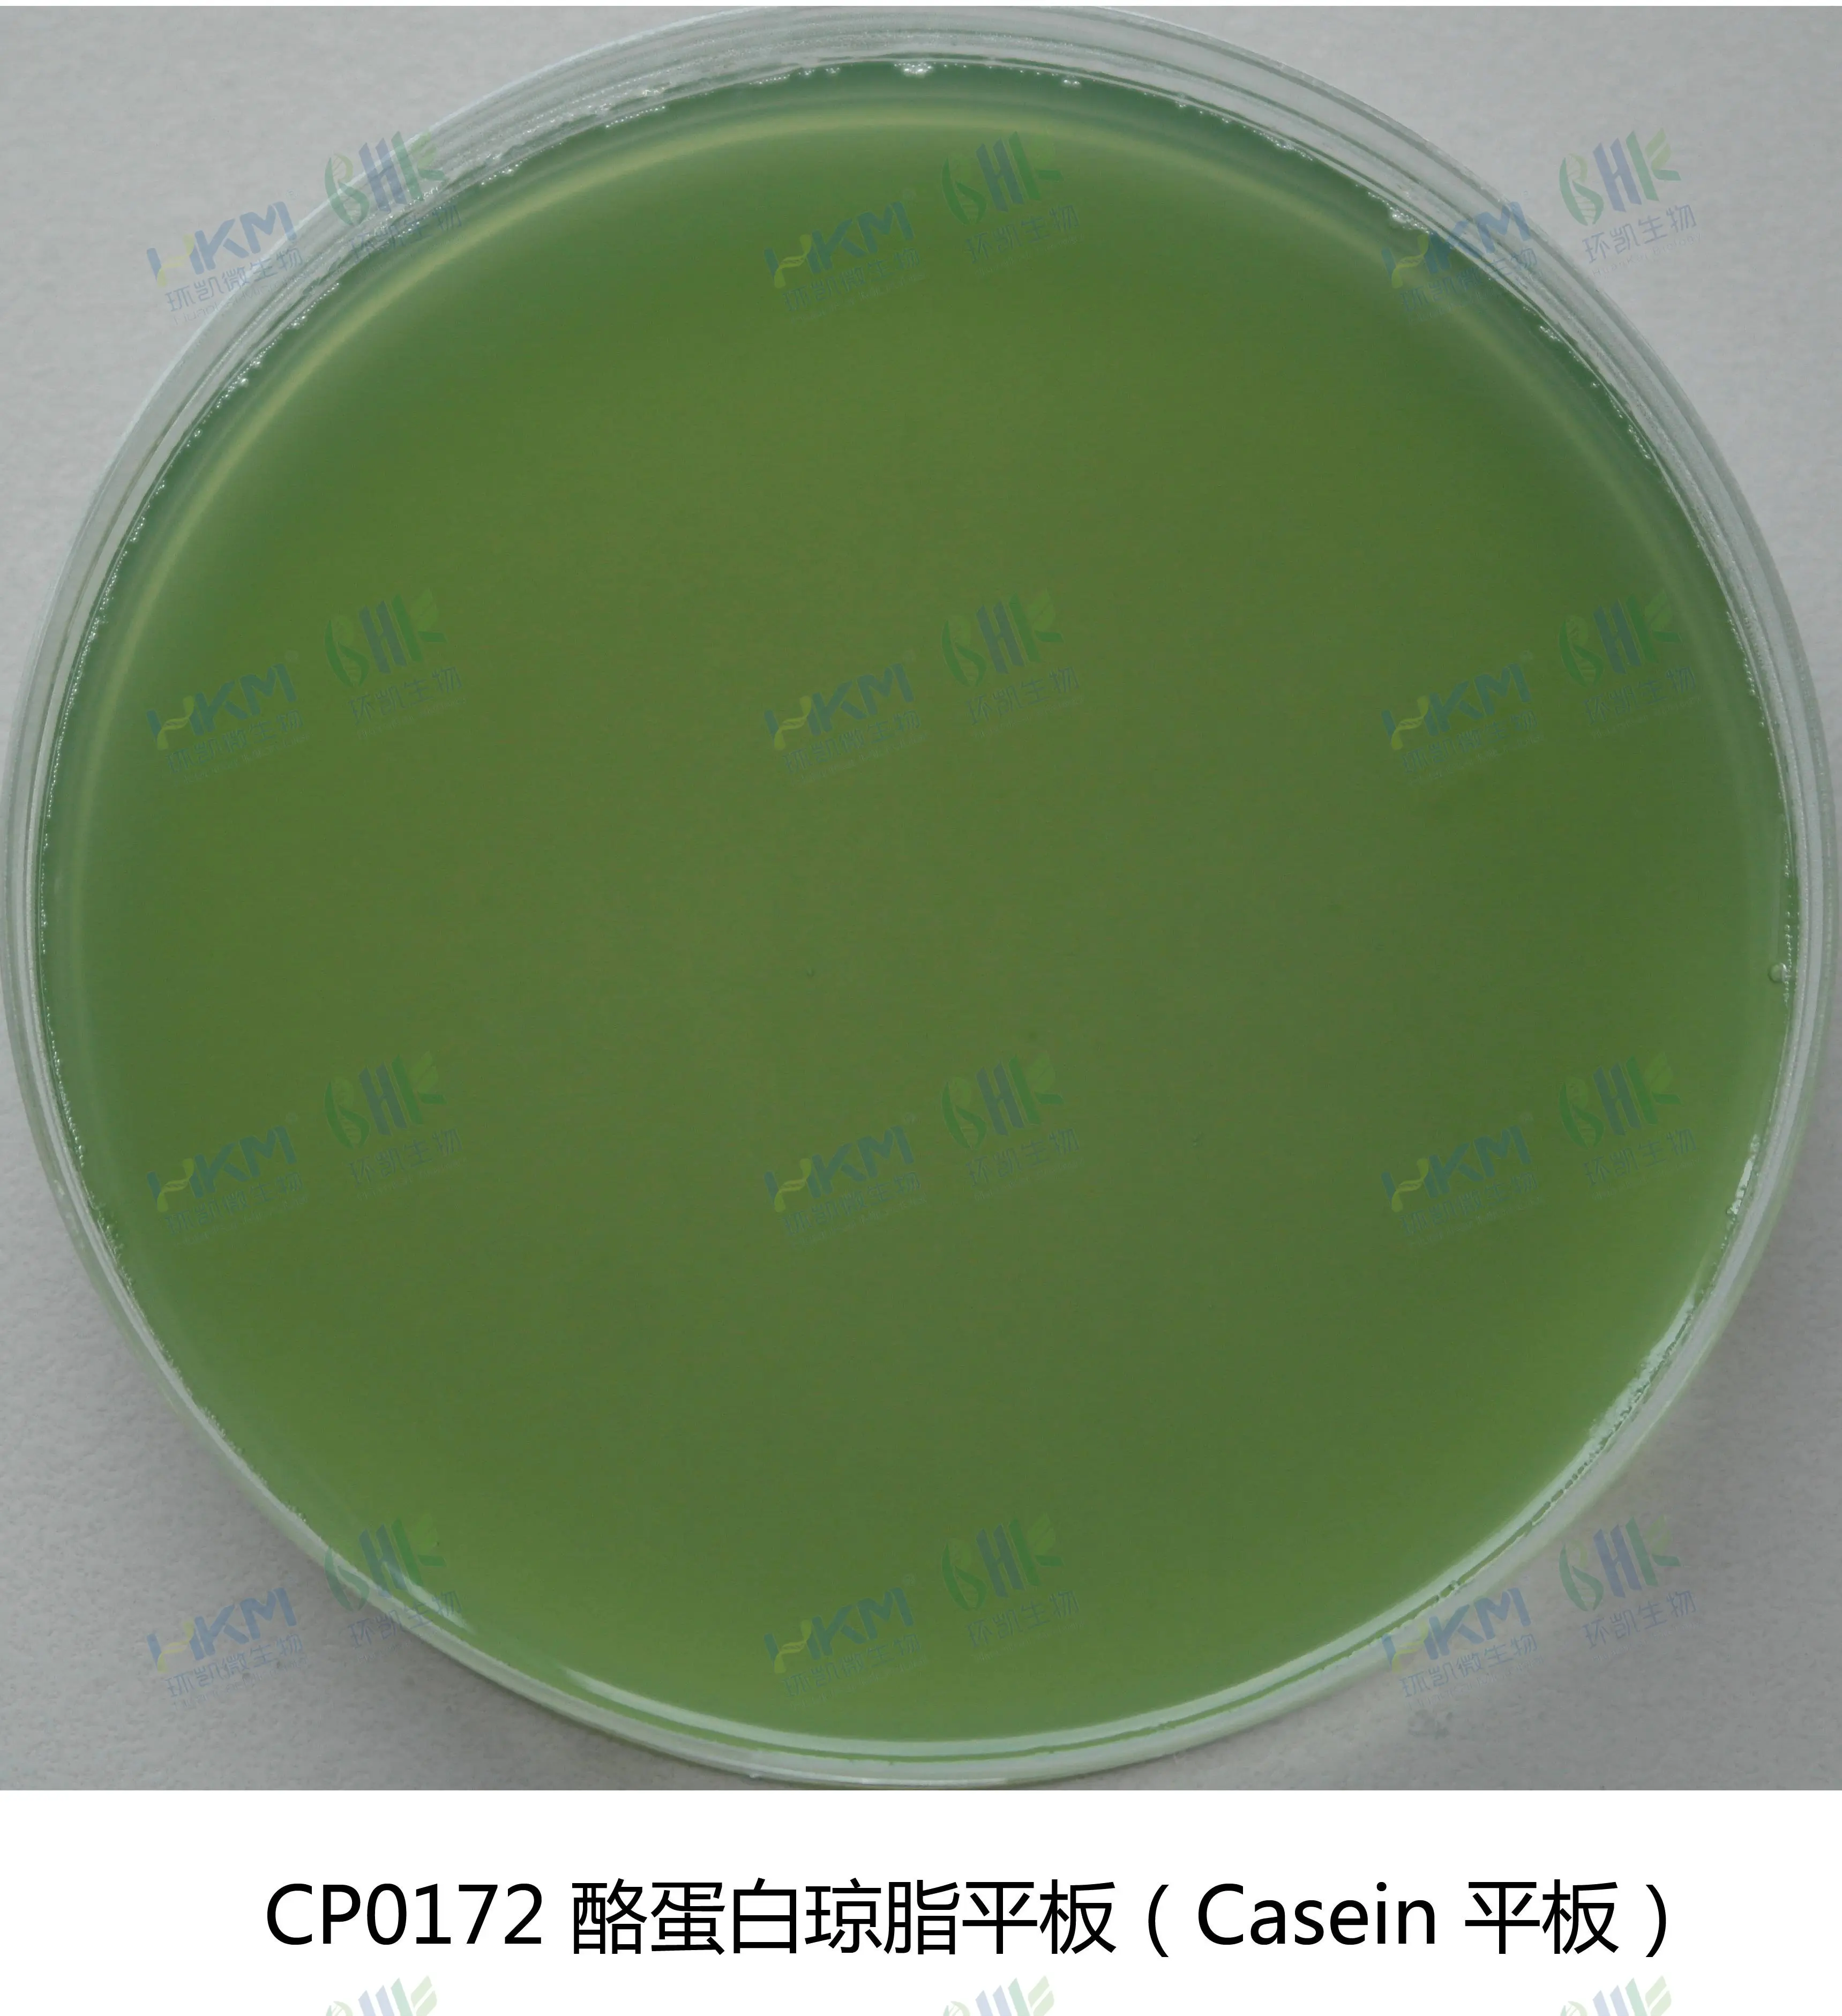
酪蛋白琼脂平板

商品详细
说明书
微生物图册
行业应用
相关论文
产品名称:酪蛋白琼脂平板
英文名称:Casein Agar Plate
产品编号与包装规格:
| 产品编号 | 产品类型 | 包装规格 |
|---|---|---|
| CP0172 | 成品平板 | 90mm×20个/盒 |
产品用途:用于鉴别蜡样芽孢杆菌分解酪蛋白试验。(GB/T4789.14)
验原理:某些细菌产生酪蛋白酶可分解酪蛋白使菌落周围的培养基形成透明圈;牛肉膏粉提供氮源、维生素和生长因子;磷酸氢二钠为缓冲剂;氯化钠维持均衡的渗透压;琼脂是培养基的凝固剂;溴麝香草酚蓝为指示剂染料。
酪蛋白琼脂平板配方成分:
| 配方 | 含量(每升) |
|---|---|
| 酪蛋白 | 10.0g |
| 牛肉膏粉 | 3.0g |
| 磷酸氢二钠 | 2.0g |
| 氯化钠 | 5.0g |
| 琼脂 | 15.0g |
| 溴麝香草酚蓝 | 0.05g |
| 蒸馏水 | 1000mL |
| 最终pH 7.4±0.2 | |
使用方法:拆开包装即可使用。
酪蛋白琼脂平板质量控制【下列质控菌株接种后于35~37℃培养24h,观察结果如下表:】
| 指标 | 质控菌株及编号 | 标准值 | 特征性反应 |
|---|---|---|---|
| 生长率 | 蜡样芽孢杆菌CMCC63303 | PR≥0.8 | 菌落周围有透明圈,培养基颜色由绿变蓝 |
| 特异性 | 大肠埃希氏菌ATCC25922 | — | 菌落周围没有透明圈,培养基由绿变蓝 |
储存条件与保质期:2-25℃避光保存,具体有效期见标签。
参考文献:GB/T 4789.14-2003 中华人民共和国国家标准 食品卫生微生物学检验 蜡样芽胞杆菌。
